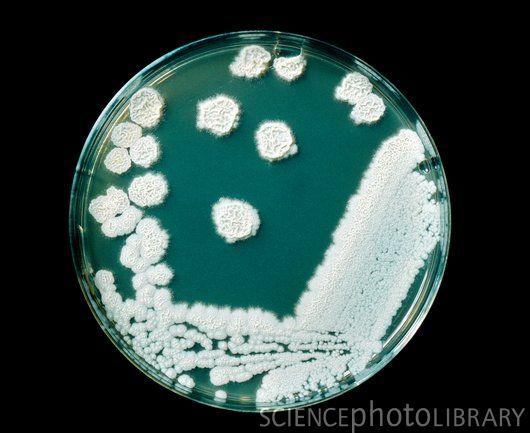

Candida krusei es una levadura del género Candida. Las células mayores son cilíndricas, de hasta 25 mm de largo. Las colonias separadas exceden con frecuencia los 5 mm de diámetro sobre malta-glucosa a 25 °C.
Es un patógeno nosocomial que principalmente afecta a los pacientes inmunodeprimidos y aquellos con neoplasias hematológicas. Tiene una resistencia natural a fluconazol, un agente antimicótico estándar. Se encuentra con mayor frecuencia en pacientes que han tenido exposición previa al fluconazol, aunque hay pruebas contradictorias acerca de si el fluconazol debe ser utilizada con fines profilácticos. La infección por C. krusei es una fungemia rara. El germen fúngico que más predomina es C. albicans. Otras especies de Candida que también encajan en este perfil son C. parapsilosis, C. glabrata,C. tropicalis, C. guillermondii, además de la C. rugosa.
Puede ser tratada exitosamente con voriconazol, anfotericina B, o las equinocandinas micafungina, caspofungina y anidulafungina. Aunque hay evidencia clínica acerca del tratamiento combinado de Anfotericina B con triazoles, aunque la Anfotericina B tiene muchos efectos adversos sistémicos.
Referencias
- Hautala T. A cluster of Candida krusei infections in a haematological unit. BMC Infectious Diseases 2007, 7:97. [1]
- Pfaller MA. Candida krusei, a multidrug-resistant opportunistic fungal pathogen: geographic and temporal trends from the ARTEMIS DISK Antifungal Surveillance Program, 2001 to 2005. J Clin Microbiol. 2008 Feb;46(2):515-21. [2]
Enlaces externos
- http://botit.botany.wisc.edu/toms_fungi/feb2006.html